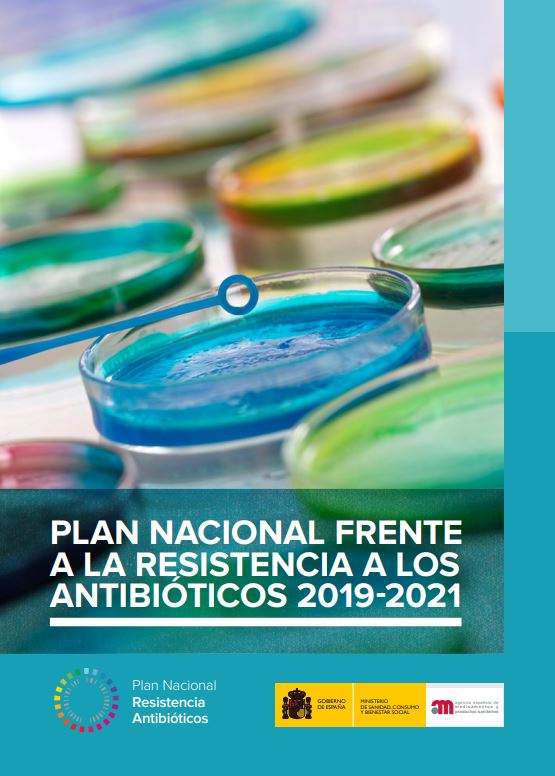
PRANGob-interior

ACTUALIDAD
El PRAN 2019-2021 recomienda el uso del Punto SIGRE
El nuevo Plan Nacional frente a la Resistencia a los Antibióticos (PRAN) 2019-2021, coordinado por la Agencia Española de Medicamentos y Productos Sanitarios (AEMPS), contempla las estrategias a adoptar durante el próximo trienio para contribuir a evitar las resistencias bacterianas y destaca la importancia de desechar en el Punto SIGRE los restos de antibióticos y sus envases al finalizar los tratamientos.
Este Plan contiene la hoja de ruta establecida por las autoridades sanitarias de nuestro país para cumplir con las directrices europeas y hacer frente a las resistencias bacterianas, uno de los principales problemas de salud pública a nivel mundial. El PRAN, cuya primera versión fue aprobada en 2014, tiene como objetivo reducir el riesgo de diseminación de las resistencias a los antibióticos para reducir el impacto de este problema sobre la salud de las personas y los animales, así como para preservar la eficacia de los antibióticos existentes en la actualidad.